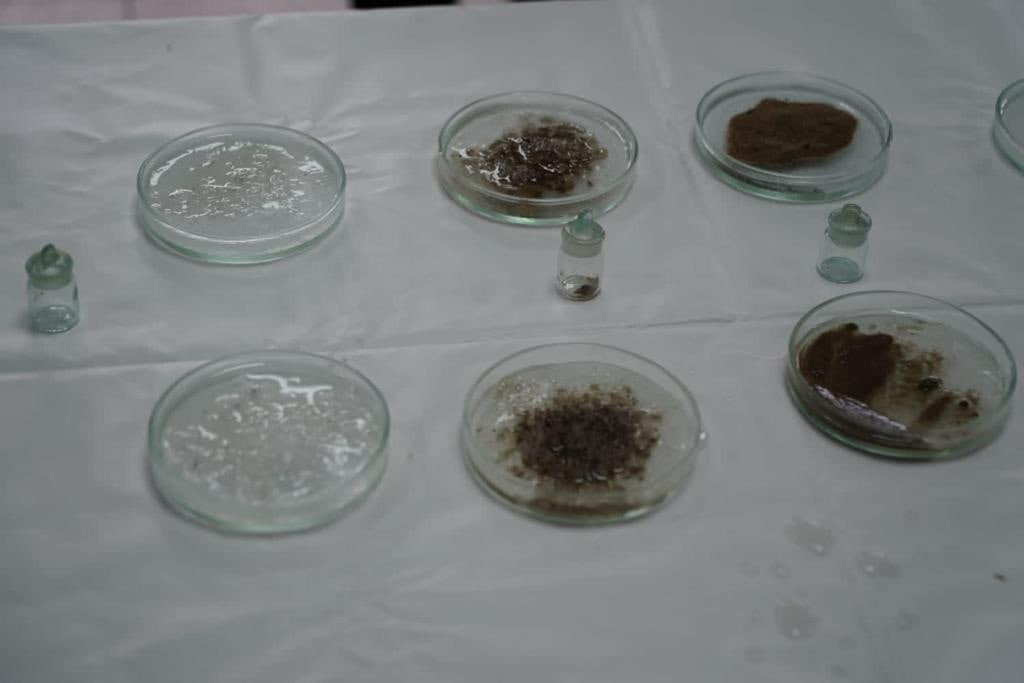

Дороги Красноярска этой зимой будут обрабатывать солью и солевыми растворами
Мэр Красноярска Владислав Логинов рассказал о подготовке к зимнему обслуживанию улично-дорожной сети города. Бороться со льдом на проезжей части будут с помощью соли и солевых растворов.
Сегодня глава города проинспектировал муниципальное предприятие "САТП". Это крупнейшая организация Красноярска, занимающаяся обслуживанием дорог. В настоящее время выйти на уборку снега готовы 130 машин. Всего автопарк предприятия насчитывает около 200 единиц. Это различная снегоуборочная, погрузочная техника, а также плавильные станции.
В этом году город получит ещё 11 машин. 8 из них предназначены для содержания дорог зимой. Вся техника приобретается в лизинг.
При этом на предприятии есть проблемы с кадровым составом. Сейчас мэрия решает, как исправить ситуацию, чтобы на улицы Красноярска в случае необходимости выходил весь автопарк.
Отдельно Владислав Логинов затронул тему обработки дорог зимой. По мнению учёных СФУ, оптимальный вариант антигололёдного средства в нашем климате - это единая гранула, включающая хлорид натрия и кальция, формиат натрия и мочевину. Однако такой реагент Роспотребнадзор запретил использовать. Мэрия продолжает в суде оспаривать это решение. Пока дороги будут обрабатывать солью, солевыми растворами и смесями с абразивными материалами.
Синоптики прогнозируют, что улицы Красноярска занесёт снегом не раньше середины ноября.

Гость (премодерация)
Войти